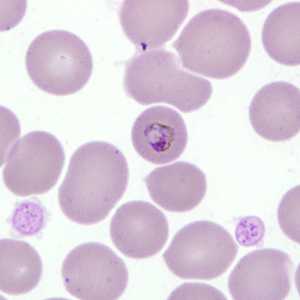
Case277_A

Monthly Case Studies - 2010
December 2010

December - 2010 - Case #289
A 47-year-old woman originally from El Salvador had been living in Minnesota for 16 years. She visited family in El Salvador for about a month during the summer. One month after returning to Minnesota, she was admitted to a local hospital for an appendectomy.

December - 2010 - Case #290
A 31-year-old man was admitted to a local hospital with fever, chills, myalgia, and fatigue. His travel history included a two week work-related trip to Cambodia and a one week vacation in Connecticut immediately after that trip.
November 2010

November - 2010 - Case #287
A 29-year-old pregnant woman from Ethiopia presented to a hospital with nausea, vomiting, abdominal pain and episodic fever. The symptoms started within a day after arriving in the United States, and had persisted for five days prior to hospitalization.

November - 2010 - Case #288
A 50-year-old man underwent a screening colonoscopy after complaints of constipation. A polyp measuring approximately 3 mm was observed during the procedure.
October 2010

October - 2010 - Case #285
A 33-year-old woman, who had traveled to Togo and Benin for two weeks, developed fever, chills, and rigors within three days after returning to the U.S.

October - 2010 - Case #286
A 21-year-old man attending a local music festival developed intermittent diarrhea and abdominal cramps on the second day. He went to his health care provider who requested a stool specimen for routine testing.
September 2010

September - 2010 - Case #283
A 49-year-old man presented to his primary care physician with a lump in his throat which had developed over the past three months. He was ultimately referred to an oral surgeon with multiple oral ulcers and submucosal nodules.

September - 2010 - Case #284
A 10-year-old immigrant from Haiti was screened for parasites at a refugee screening clinic. Stool specimens were collected in 10% formalin and polyvinyl alcohol and sent to the local state health laboratory for testing.
August 2010

August - 2010 - Case #281
A 25-year-old man, who lives in the Midwestern United States, went to his health care provider with complaints of abdominal pain over the last month. A stool specimen preserved in 10% formalin was submitted for ova-and-parasite (O&P) testing.

August - 2010 - Case #282
A 49-year-old man with AIDS was admitted to the hospital for complaints of a persisting fever and dry cough. A chest radiograph showed bilateral infiltrate. A sputum specimen was collected and stained with Giemsa, but no parasites were observed.
July 2010

July - 2010 - Case #279
While examining a malaria-positive smear on a patient from Uganda, microbiologists at the Ontario Agency for Health Protection and Promotion observed what they believed to be a microfilaria. Images were captured and sent via email to the DPDx Team for diagnostic assistance.

July - 2010 - Case #280
A 35-year-old woman went to her health care provider with complaints of abdominal pain, cramps and diarrhea. She told her doctor that she had recently returned from a business trip to Mexico. Stool was collected in 10% formalin and polyvinyl alcohol (PVA) for routine ova-and-parasite (O&P) examination.
June 2010
June - 2010 - Case #277
A 29-year-old female went to her health care provider with complaints of fever and headache, two weeks after returning home from trips to Uganda and Sudan. She admitted that she only took malaria prophylaxis whenever she did not feel well.

June - 2010 - Case #278
DPDx is moving! Along with the all of the laboratories within the Division of Parasitic Diseases and Malaria at the CDC! We want to take this opportunity to let you know that although actual specimen receiving and testing will be temporarily interrupted for about a week or two, DPDx will continue to provide telediagnosis assistance via the internet.
May 2010

May - 2010 - Case #275
A 70-year-old female, who had recently returned from a trip to Madagascar, went to the hospital for a painful sensation on the underside of her left foot while walking. Examination of the area between the hallux and index toes revealed an ulcerative lesion.

May - 2010 - Case #276
The DPDx Team received stained stool smears from the Vermont Department of Health Laboratory for Entamoeba identification. The patient was a 12-year-old refugee from Myanmar who had also traveled to Malaysia.
April 2010

April - 2010 - Case #273
A 68-year-old man underwent a routine colonoscopy at a local V. A. Medical Center. He had no complaints of illness but had recently traveled to Ethiopia. A worm-like object measuring approximately 30 millimeters in length was observed and recovered.

April - 2010 - Case #274
A patient from Pakistan was admitted to a medical facility with non-cirrhosit portal hypertension, hepatic vein thrombosis, IVC stenosis and respiratory failure. No eosinophilia was reported at the time patient was admitted, but was present at 7% the next day.
March 2010

March - 2010 - Case #271
The DPDx Team received Giemsa-stained blood smears from a state health laboratory for malaria confirmation/identification. The patient travels internationally regularly for business, and within the month before becoming ill, had traveled to India, Malaysia and China.

March - 2010 - Case #272
A 35-year-old male from the United Arab Emirates was hospitalized with complaints of upper and lower abdominal pain. Sections of the greater omentum and appendix were biopsied and sent to a pathology laboratory for sectioning and staining.
February 2010

February - 2010 - Case #269
A 29-year-old woman had complaints of abdominal cramping and diarrhea that had been persisting for 5 days. She went to a local clinic to determine what was causing her illness.

February - 2010 - Case #270
A six-year-old boy was taken to a local clinic for abdominal discomfort. A stool specimen was collected in formalin for routine ova-and-parasite (O&P) examination.
January 2010

January - 2010 - Case #267
A 13-year-old patient went to the doctor for abdominal pain and discomfort. Although there was no acute appendicitis, a small biopsy of the lumen of the appendix was performed to identify possible etiologies.

January - 2010 - Case #268
A woman residing in the eastern United States brought to her doctor a tick, which she claimed was removed from her husband after he had spent the weekend doing yard work.
DPDx is an education resource designed for health professionals and laboratory scientists. For an overview including prevention and control visit www.cdc.gov/parasites/.
- Page last reviewed: September 2, 2016
- Page last updated: September 2, 2016
- Content source:
- Global Health – Division of Parasitic Diseases and Malaria
- Notice: Linking to a non-federal site does not constitute an endorsement by HHS, CDC or any of its employees of the sponsors or the information and products presented on the site.
- Maintained By:


 ShareCompartir
ShareCompartir